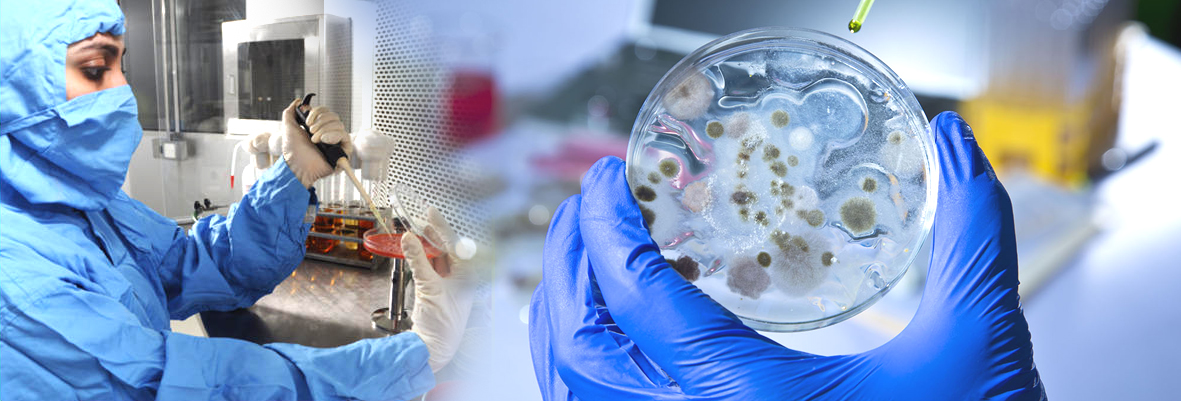

JEEVA LIFE SCIENCES.. is a leading DCA approved testing laboratory. An ISO 9001:2015 certified organization also registered at Committee for the Purpose of Control & Supervision of Experiments on Animals (CPCSEA) research for commercial testing purpose, trade & supply of small laboratory testing animals (Rat, Mice, Guineapigs & Rabbits). We are implementing good Laboratory Practices as per IAEC Committees & ICH guidelines, providing best analytical services 𝘪𝘯𝘷𝘪𝘷𝘰 & 𝘪𝘯𝘷𝘪𝘵𝘳𝘰 to all clients/ patrons who are in the field of Research & Development, manufacturers of Bulk Drugs, API’s, Formulations, Medical Disposable devices, Various Government & Research organizations, Hospitals, Food Industries etc..
Our experienced Business Development team can handle and coordinate with the Industry in highly organised way.